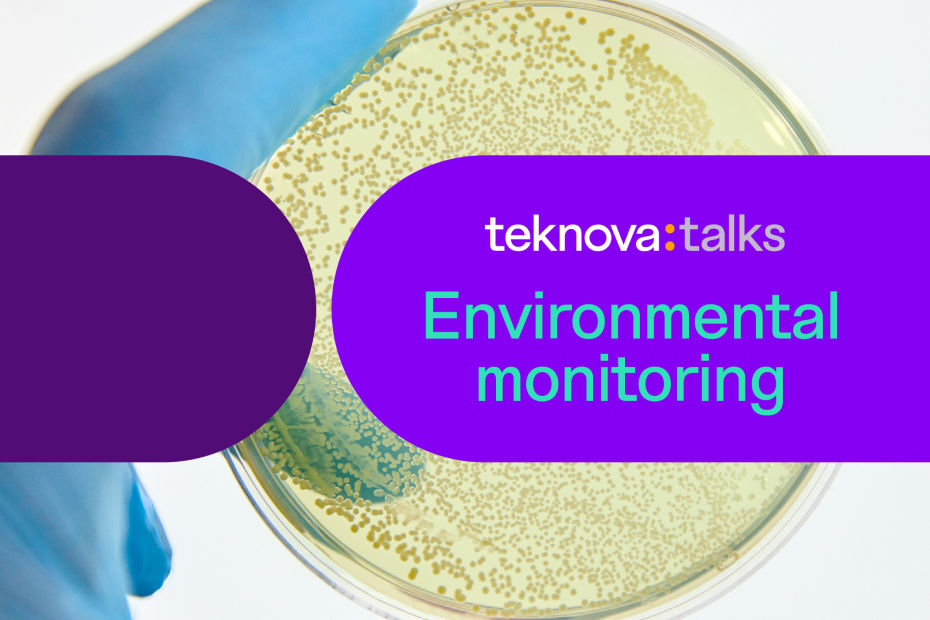
Teknova Talks: Enivronmental Monitoring

INTRODUCTION
How culture media supports your microbial monitoring
Agar plates are essential tools for monitoring for potential microbial contaminants in controlled environments. Used most frequently in the life sciences and food manufacturing, they provide a nutrient-rich growth medium that serves as an alert system, letting you know if microorganisms are present. Specialty and selective media can also be used for the characterization and identification of microbial species based on their metabolic traits.
There are a variety of ways to monitor your environment, and we can help you find the ideal media to use for your specific application.
Standard settle plates
Designed to be your first line of detection of microbial contamination, these are the same high-quality plates we use to maintain sterility in our own cleanrooms. They are ideal for monitoring ISO 8 and ISO 9 facilities, including formulation rooms, washrooms, and other ancillary environments.
Available in two formulations, our off-the-shelf settle plates come shrink-wrapped and single-bagged for convenient material transfer into your ISO 8 and ISO 9 cleanrooms. Their unique green color makes them easy to see when you are fully gowned and distinguishes them from any other plates you may be using in your workflow.
SEE ALL PRODUCTS
Explore our full selection of environmental monitoring products
We offer a wide variety of pre-poured agar plates, as well as supporting products like microbial culture media and wash solutions. To help you get the ideal fit for your specific application, we can customize everything from formulation to format to fill volume.
Endo LES Media is a specialized media used for accurate coliform enumeration in water samples. This two-step process involves initial sample resuscitation and enrichment in Lauryl Tryptose Broth, followed by plating on modified Endo agar. The medium's selectivity is achieved through specific agents like sodium desoxycholate and sodium lauryl sulfate, which inhibit non-coliform growth while enabling the selective growth of coliforms. Additionally, it is differential, allowing differentiation based on lactose fermentation at 35°C. Coliforms on m-Endo LES Agar appear as red colonies with a metallic green sheen due to aldehyde production during lactose fermentation.
Incubation 22-24 hours at 35-37°C
m-ENDO LES agar was developed for the quantitative enumeration of coliform microorganisms. This is important in water testing, where the concentration of certain microorganisms, like coliform bacteria, can indicate the degree of fecal contamination and the potential risk to human health.
Fluid A (or Sterility Fluid A) is a sterile, non-selective liquid medium used in microbiological and sterility testing procedures. It is primarily used during the surface cleaning step to capture potential contaminants. It is also able to enhance the sensitivity of sterility tests as it contains peptone, a nutrient source derived from protein hydrolysates, which provides essential nutrients that support the growth and metabolism of viable microorganisms. After the surface cleaning step, Fluid A is aseptically transferred to sterility test media, facilitating the detection and identification of any microbial growth.
Fluid D is used in sterility testing procedures to efficiently dilute or rinse samples that may contain lecithin or oil. This medium consists of peptone water combined with polysorbate 80, which enhances its effectiveness in the dilution and rinsing processes during sterility testing. The presence of polysorbate 80 in its composition serves as a surfactant, aiding in the breakdown of lecithin or oils that may be present in the samples. This contribution leads to more accurate and reliable sterility test results. Importantly, the composition of the medium does not pose any toxicity to microorganisms.
Fluid Thioglycollate Medium serves as a versatile liquid enrichment medium, facilitating the isolation and cultivation of aerobes, anaerobes, and microaerophiles without strict fastidious requirements. Its unique composition promotes the growth of anaerobes without requiring specialized anaerobic incubation. With components including glucose, peptone, yeast extract, sodium thioglycollate, L-cystine, and resazurin, it can supply essential growth factors, prevent harmful peroxide accumulation in specific microorganisms by reducing the oxidation-reduction potential, and neutralize the antibacterial effects of mercurial compounds. This makes it an indispensable tool for assessing contamination in a wide variety of materials.
MacConkey Media is a selective and differential media composed of peptone, lactose, bile salts, neutral red, crystal violet, and agar. It serves a dual purpose by inhibiting gram-positive bacteria and enabling the isolation of gram-negative bacteria, with a specific focus on coliform enumeration. Lactose fermenters, which include coliforms, produce red colonies due to acid byproduct formation, aiding in their identification, while non-fermenters typically form colorless colonies. Additionally, MacConkey Media can support the growth of certain pathogenic bacteria like Escherichia coli (E. coli).
It is typically incubated at 30-35°C for 18-72 hours.
Mannitol Salt Agar (MSA) is a selective and differential media used for isolating pathogenic Staphylococci. Its selectivity comes from its high salt concentration, which inhibits the growth of most bacteria while permitting the growth of Staphylococci that can tolerate such salt levels. MSA's differential characteristic is attributed to the inclusion of mannitol (a sugar alcohol) and a pH indicator (usually phenol red). Staphylococcus aureus ferments mannitol, leading to the production of acid, which lowers the medium's pH and causes a color change from red to yellow. This color change serves as a key indicator for the presence of Staphylococcus aureus and aids in its differentiation from other staphylococci.
It is typically incubated at 30-35°C for 18-72 hours.
MRS Media (also know as de Man, Rogosa, and Sharpe) is a specialized microbiological growth media used for isolating and cultivating lactic acid bacteria, including Lactobacillus and Bifidobacterium species. Lactose is a key component in MRS Media, serving as a substrate for fermentation by lactic acid bacteria. During fermentation, lactic acid bacteria metabolize lactose, producing lactic acid, which is a distinguishing characteristic of these microorganisms and serves as a diagnostic marker for their presence in microbiological samples.
It is typically incubated at 37°C for 48 hours. Most lactic acid bacteria form visible colonies within 24-48 hours of incubation. However, some slower-growing strains may require longer incubation times.
Nutrient Media is versatile and non-selective media that supports the growth of a broad spectrum of microorganisms, including bacteria, fungi, and some yeast species. It contains peptones (partially digested proteins) and beef extract that provide essential nutrients, carbon, and energy sources necessary for microbial growth. It is particularly valuable for the isolation of individual microbial colonies from mixed cultures, aiding in the purification and identification of specific microorganisms. Its non-selective nature ensures that a wide array of microorganisms can thrive, making it an ideal choice for general microbial cultivation, educational purposes, and preliminary assessments of environmental or clinical samples.
It is typically incubated at 35-37°C for 18-24 hours.
- Plates
- Broths
Plate Count Media, also known as Plate Count Agar (PCA) or Standard Methods Agar (SMA), is a widely used microbiological growth medium ideal for quantifying viable bacterial growth in testing samples. It is considered a non-selective medium as it does not preferentially promote the growth of specific bacterial types. Its unique composition includes casein, which serves as a source of nitrogen, carbon, amino acids, vitamins, and minerals, facilitating bacterial growth.
PCA is commonly used for a Standard Plate Count test (also known as a Total Plate Count test) to determine the total viable bacterial count in a testing sample. The test involves sample dilution and incubation of the plates for approximately 3 days at a temperature ranging from 20-30°C, with quantification of bacterial colonies as Colony Forming Units per gram (CFU/g) in solid samples and Colony Forming Units per milliliter (CFU/ml) in liquid samples.
Potato Dextrose Agar (PDA) is a general-purpose agar that encourages fungal growth. It provides a rich source of nutrients, including carbohydrates from dextrose and other essential components, that support the growth of various fungal species, particularly yeasts and molds. The low pH (typically around 3.5) helps inhibit the growth of many bacteria while allowing fungi to grow. This makes it particularly valuable for the examination of environmental and food samples for fungal contamination, the maintenance of fungal cultures, and the study of fungal morphology and physiology.
It is typically incubated at 22-25°C or 30-32°C (depending on the type of fungi) for 2-7 days or longer. Yeast grow as creamy to white colonies, while molds will grow as filamentous colonies of various colors.
Pseudomonal Agar, also known as Cetrimide Agar, is a specialized culture medium with both selective and differential properties, predominantly used for the isolation and identification of Pseudomonas aeruginosa. It contains cetrimide, which serves as a selective agent that inhibits the growth of many bacteria while promoting the growth of Pseudomonas species, particularly Pseudomonas aeruginosa. Pseudomonas bacteria produce pyocyanin, a bluish-green pigment, and in some strains, red pyorubin or black pyomelanin pigments, which diffuse into the surrounding medium, creating distinct colors around the bacterial colonies.
It is typically incubated at 35 °C for up to 7 days, checking for bacterial growth after 24, 48, 72, and 144 hours.
R2A Media is ideal for various bacterial enumeration techniques, including pour plate, spread plate, and membrane filter methods used for heterotrophic plate counts. It has gained popularity in microbiological testing procedures used to monitor the quality of drinking water systems due to its unique ability to recover stressed and chlorine-tolerant bacterial species found in treated water. This gives it an advantage over nutrient-rich media such as Tryptone Glucose Yeast Extract Agar or Plate Count Agar (Standard Methods Agar), which can often overlook or suppress slow-growing or stressed bacteria.
R2A is commonly used to perform a Heterotrophic Plate Count (HPC) test to determine the total number of viable heterotrophic bacteria in a given sample. This test involves incubating samples at a lower temperature to encourage the growth of stressed and chlorine-tolerant bacteria over an extended period, typically 5-7 days. After incubation, bacterial colonies are counted, and the results are expressed as colony-forming units (CFUs) per milliliter of the original sample.
Rappaport-Vassiliadis (RV) Media is a selective medium primarily used for the enrichment and detection of the Salmonella species. Its effectiveness relies on specific conditions that include elevated osmotic pressures, lower pH levels, higher temperatures, and relatively modest nutritional demands. It also contains selective agents such as malachite green and novobiocin, which inhibit the growth of most competing bacteria, creating a favorable environment for Salmonella to thrive. RV media is particularly valuable for the rapid detection of Salmonella, allowing stressed or damaged Salmonella cells to recover and grow.
The typical ratio of inoculum to broth is 1:100, with an incubation temperature of 41–42°C for 18–24 hours.
Reinforced Clostridial Agar (RCA) is an enriched non-selective medium specially designed for the cultivation of Clostridia and other anaerobic and facultative bacteria. Its nutritive base consists of casein, beef extract, and yeast extract, providing a rich source of carbon, nitrogen, vitamins, and essential minerals. Dextrose is incorporated to supply carbohydrates, while L-Cysteine serves as a reducing agent. Soluble starch functions as a detoxifier of metabolic by-products, and sodium acetate acts as a buffer.
It is typically incubated at 35-37°C for 48-96 hours under anaerobic conditions, facilitating selective bacterial cultivation and growth.
Rose Bengal Agar (RBA) is a selective and differential media, commonly used for the isolation and identification of pathogenic yeasts and molds, such as the Candida species. Its selectivity comes from the inclusion of rose bengal dye, which inhibits bacterial growth while allowing for the proliferation of fungi. The colonies that grow on RBA have distinct colors and morphologies, aiding in the identification of various yeast and mold species. Yeast colonies typically appear creamy to pink, while molds manifest in an array of colors such as green, black, or brown.
It is typically incubated in the dark at 25-30°C for 3-5 days.
Sabouraud Dextrose Media is a specialized culture media widely used for the isolation and cultivation of yeasts and molds (fungi) that may be present in environmental samples. It is comprised of peptone, dextrose (glucose), agar, and a pH indicator, which provide the essential nutrients and a solidifying matrix for fungal or yeast growth. Saboraud Dextrose Agar with Chloramphenicol (SDA with C) includes chloramphenicol, an antibiotic that inhibits bacterial growth, making it more selective for fungi and yeast.
It is typicaly incubated at 20-25°C for fungi and 30-37°C for yeasts. Incubation time can vary from 48 hours to several weeks, depending on the specific microorganism being tested. Following incubation, further identification and characterization of the isolated fungi or yeasts can be performed using microscopy and biochemical techniques.
Salmonella-Shigella Media is a selective and differential medium used to isolate and differentiate Salmonella and Shigella species. It achieves selectivity by inhibiting gram-positive bacteria growth with bile salts and brilliant green dye. It provides essential nutrients through beef extract and enzymatic digests, while sodium thiosulfate generates H2S gas, seen as a black precipitate. Lactose fermentation causes a color shift to red due to neutral red, helping distinguish lactose fermenters (red colonies) from non-fermenters (colorless colonies). Salmonella colonies are colorless with a black center, and Shigella colonies are colorless without the black center.
It is typically incubated at 35-37°C for 18-24 hours.
Tryptic Soy Media (TSA and TSB) is a nutrient-rich general-purpose culture medium widely used in microbiology for the cultivation and isolation of both fastidious and non-fastidious microorganisms, making it suitable for the membrane-filter technique. It is compatible with the growth of both aerobic and anaerobic bacteria, and is composed of casein peptone and soya peptone, which provide nitrogen, vitamins, minerals, and natural sugars that promote bacterial growth. Sodium chloride is added to maintain osmotic balance. It lacks the X and V factors required for the identification of Haemophilus species, however X (Hemin) and V (DPN) factor strips can be added.
It is typically incubated at 20°C-37°C, depending on the specific microorganisms being cultivated, with incubation times of 18-24 hours.
- Plates
- Broths
Xylose Lysine Deoxycholate (XLD) is a selective culture medium with a unique composition used in microbiological analysis for the isolation and differentiation of Salmonella and Shigella species. The selective and differential properties of XLD are due to the presence of indicators that react with the metabolic byproducts of Salmonella and Shigella, resulting in characteristic colony appearances.
It is typically incubated at 35-37°C for 18-24 hours.
Discover more resources